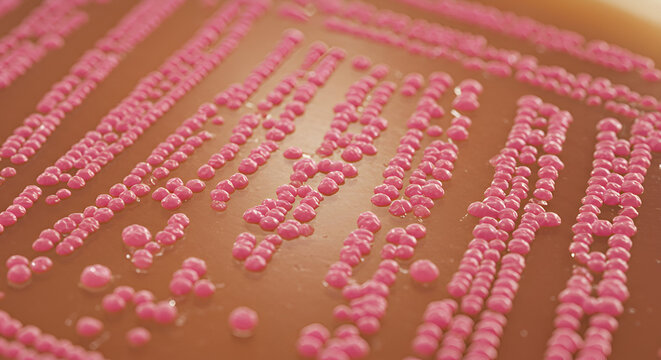
Bacterial Culture on MacConkey Agar Showing Lactose Fermenters
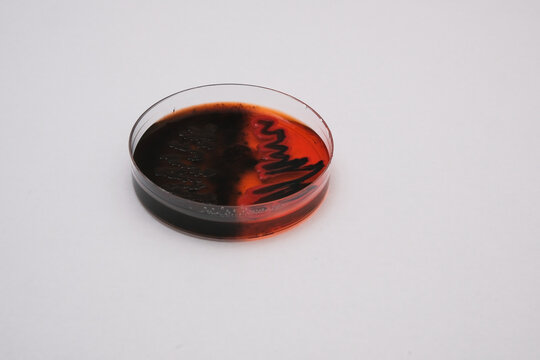
photo of growth of black bacterial colonies on macconkey agar
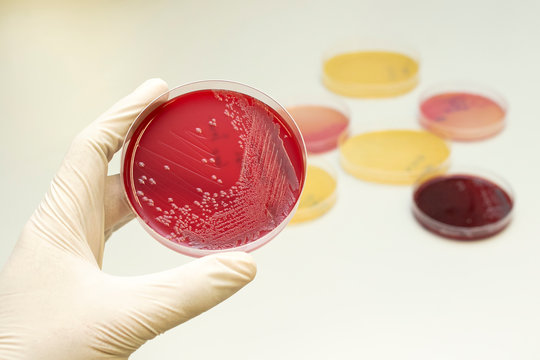
Hand holding petri dish with Escherichia coli (E. coli) culture in macconkey agar. Bacterium culture growth in glassware. Medical tests in laboratory.
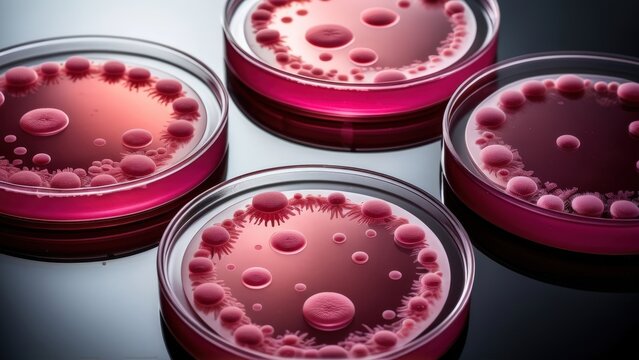
E. coli colonies on MacConkey agar, metallic pink bacterial growth stands out on a glossy agar surface, with lab equipment reflections adding a scientific atmosphere.
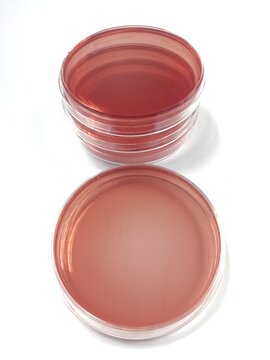
MacConkey agar, a selective and differential culture medium for bacteria

新しいフィルターが追加されました
並べ替え
地域を選択してください
選択した地域によって、Adobe Stock Web サイトに表示される言語やプロモーションの内容が異なる場合があります。
北米
南米
- Venezuela
- Algeria - English
- Armenia - English
- Azerbaijan - English
- Bahrain - English
- Belgium - English
- Belgique - Français
- België - Nederlands
- Česká republika
- Croatia - English
- Cyprus - English
- Danmark
- Georgia - English
- Deutschland
- Eesti
- Egypt - English
- España
- France
- Greece - English
- Iceland - English
- Ireland
欧州、中東、アフリカ
- Israel - English
- Italia
- Jordan - English
- Казахстан
- Kenya - English
- Kuwait - English
- Киргизия
- Latvija
- Lebanon - English
- Lietuva
- Luxembourg - Deutsch
- Luxembourg - English
- Luxembourg - Français
- Mauritius - English
- Moldova - English
- Hungary - English
- Malta - English
- Morocco - English
- Nederland
- Nigeria
- Norge
- Oman - English